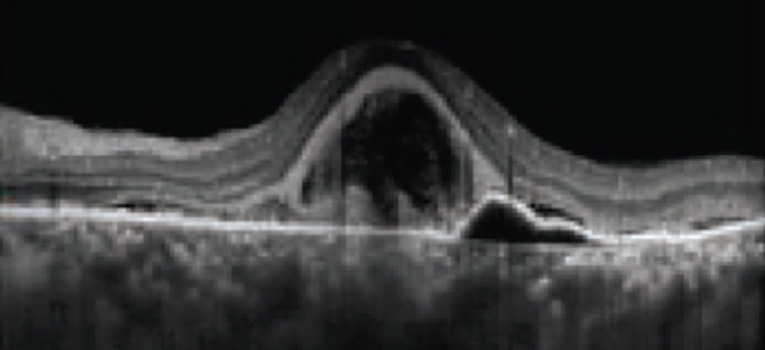
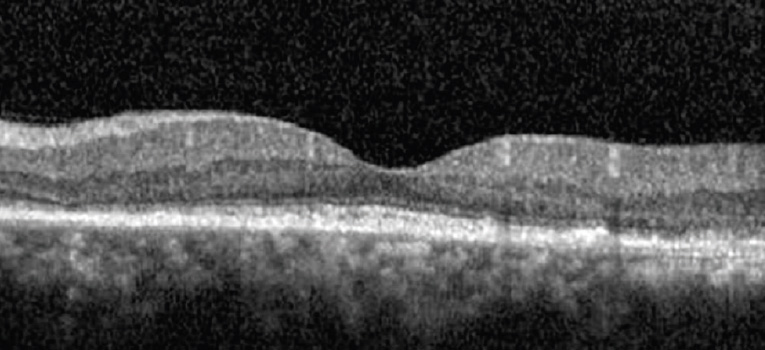

IQ577® Laser System
True – Yellow 577nm Laser mit MicroPulse® Technologie
Die guten Transmissionseigenschaften der gelben Wellenlänge, die geringen Streuverluste und dem Absorbtionsmaximum in Oxyhämoglobin ist „Gelb“ – die ideale Wellenlänge für retinale Lasertherapien. Gelb wird nicht von Xanthophyll absorbiert, deshalb ist ein sicheres lasern in Fovea-Nähe möglich. Gegenüber dem klassischen Argonlaser und den grünen Wellenlängen, kann mit deutlich weniger Energie gearbeitet werden um den gleichen Lasereffekt zu erreichen. Dies führt zu einem geringerem Schmerzempfinden für den Patienten und erhöht den Patientenkomfort.

Mit dem Einsatz der weltweitpatentierten und geschützten Fovea Friendly™ MicroPulse® Technologie eröffnen sich völlig neue Behandlungsoptionen bei folgenden Retinopathien:
- Einsatz als primäre oder adjuvante Therapie bei diabetischem Makula Ödem, CSR, Makula Ödem assoziiert mit zentralem Venen oder Venen-Ast-Verschluss, Cystoides Makulaödem, chronisch und rezidivierend, juxtafoveale Teleangiektasie, feuchte AMD
- Erfolgreiche Behandlung von Anti-VEGF-Non-Responder Patienten, sicher wiederholbar
- Keine Tachyphylaxis, keine sekundären Atrophien durch den Einsatz von Anti VEGF-Präparaten
- Früher Behandlungsansatz bei Patienten mit noch guten funktionellen Eigenschaften, aber bereits morphologischen Veränderungen der Netzhaut, wo man in der Regel noch nicht mit einer Anti-VEGF-Therapie beginnen würde
- In Kombination mit Anti-VEGF-Therapie deutliche Reduktion der Anzahl von Injektionen
- Keine Bedenken zur Behandlung bei Schwangeren oder Glaukom-Patienten
- geringere Belastung für den Patienten durch weniger Injektionen, erhebliche Kosteneinsparung
Die Fovea Friendly™ MicroPulse® Lasertherapie erlaubt auch die Behandlung von schwierigen Fällen, in denen die Fovea mit involviert ist. Nach einer MicroPulse® Laserbehandlung kommt es zu keinen morphologischen Veränderungen, der Zerstörung von neurosensorischen Netzhautschichten, weder im OCT, der Angiographie, Autofluoreszenz, oder im Funduskop, nachweisbar. Es entstehen keine typischen Lasernarben und Skotome mit entsprechenden Visus-Beeinträchtigungen.

VA 20/25 CMT 204μm
MicroPulse® Laser Behandlung über der Fovea nach chronisch bullöser RCS. Keine Zerstörung von neurosensorischen Netzhautschichten, keine Lasernarben-Skotome
Lasern über der Fovea ist mit dem Iridex MicroPulse® Laser sicher und kann bei entsprechender Indikation mit in die Behandlung eingeschlossen werden (FDA-zugelassen). Die thermische Stimulation des RPE dient als biologischer Schlüsseltrigger für den Abbau von Flüssigkeitsansammlungen einer ödematösen Retina. Entstehende Heat Shock Proteine haben eine stimulierend proliferierende und protektive Wirkung und bewirken eine „Upregulation“ von angiogenen Inhibitoren sowie eine „Downregulation“ von VEGF.
Der Laser lässt sich weiterhin für alle Anwendungen der Retinopexie im konventionellen CW-Mode sowie zur panretinalen Laserkoagulation PRP, sehr effizient mit dem Pattern-Scanner und in Verbindung mit dem TXCell Modul einsetzen. So lassen sich 2000 bis 3000 Laserherde in einer Sitzung, innerhalb von weniger als 10 Minuten applizieren.
Eine weitere Behandlungsoption ist die MicroPulse® Laser Trabekuloplastik, MLT zur Behandlung von Offenwinkelglaukomen. In verschiedenen Studien konnten Drucksenkungen zwischen 25 und 30% bei einer Responder Rate von über 70% erreicht werden. Ideal ist der Einsatz hier bei beginnenden oder mäßigen Glaukomen, auch um die Anzahl der Glaukom Tropfen zu reduzieren. Der Einsatz der MicroPulse®Technologie zeigt hier keinen koagulativen Gewebeschäden und Vernarbungen, der Arzt hält sich alle weiteren medikamentösen und operativen Behandlungsmethoden offen. Die MLT ist sicher und wiederholbar nahezu schmerzfrei, nennenswerte Nebenwirkungen treten nicht auf.



